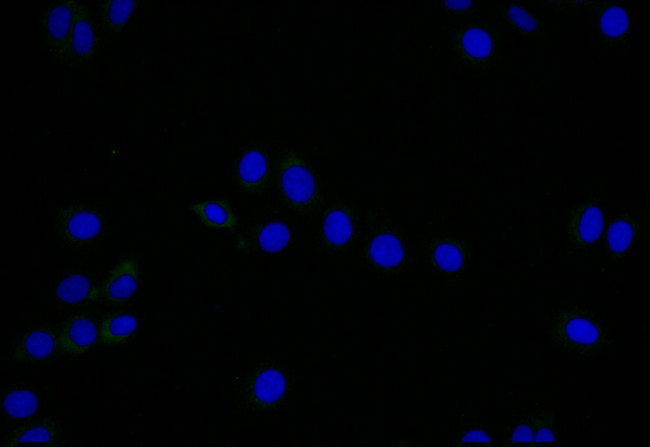
LYVE1 Antibody in Immunocytochemistry (ICC/IF)

Search
Invitrogen
LYVE1 Recombinant Rabbit Monoclonal Antibody (11C11)
{{$productOrderCtrl.translations['antibody.pdp.commerceCard.promotion.promotions']}}
{{$productOrderCtrl.translations['antibody.pdp.commerceCard.promotion.viewpromo']}}
{{$productOrderCtrl.translations['antibody.pdp.commerceCard.promotion.promocode']}}: {{promo.promoCode}} {{promo.promoTitle}} {{promo.promoDescription}}. {{$productOrderCtrl.translations['antibody.pdp.commerceCard.promotion.learnmore']}}
图: 1 / 2
LYVE1 Antibody (MA5-50148) in ICC/IF


Please note: We are reviewing Western blot images included in the antibody testing data in our catalog, including those provided by third parties. Unless expressly labeled or annotated as “raw-unedited”, Western blot images included in the antibody testing data in our catalog may have been edited, optimized or otherwise adjusted for presentation.
产品信息
MA5-50148
种属反应
宿主/亚型
Expression System
分类
类型
克隆号
抗原
偶联物
形式
浓度
规格
纯化类型
保存液
内含物
保存条件
运输条件
RRID
靶标信息
LYVE1 has been identified as a major receptor for HA (extracellular matrix glycosaminoglycan hyaluronan) on the lymph vessel wall. The deduced amino acid sequence of LYVE1 predicts a 322-residue type I integral membrane polypeptide 41% similar to the CD44 HA receptor with a 212-residue extracellular domain containing a single Link module, the prototypic HA binding domain of the Link protein superfamily. Like CD44, the LYVE1 molecule binds both soluble and immobilized HA. However, unlike CD44, the LYVE1 molecule colocalizes with HA on the luminal face of the lymph vessel wall and is completely absent from blood vessels. Hence, LYVE1 is the first lymph-specific HA receptor to be characterized and is a uniquely powerful marker for lymph vessels themselves. LYVE1 is a type I integral membrane glycoprotein. LYVE-1 is expressed primarily on lymphatic vessel endothelium and is likely to be involved in regulating the traffic of leucocytes and tumor cells to lymph nodes. The lymphatic vasculature forms a second circulatory system that drains extracellular fluid from the tissues and provides an exclusive environment in which immune cells can encounter and respond to foreign antigen. A number of molecules have been identified as markers for lymphatic endothelium which include LYVE1, PALE, VEGFR3, and podoplanin. Diseases associated with LYVE1 dysfunction includes Complete Androgen Insensitivity Syndrome.
仅用于科研。不用于诊断过程。未经明确授权不得转售。
篇参考文献 (0)
生物信息学
蛋白别名: Cell surface retention sequence-binding protein 1; CRSBP-1; Extracellular link domain-containing protein 1; Hyaluronic acid receptor; Lymphatic vessel endothelial hyaluronic acid receptor 1; LYVE-1; sLyve 1; sLyve1; soluble LYVE 1; soluble LYVE1
基因别名: CRSBP1; HAR; LYVE1; UNQ230/PRO263; XLKD1
Entrez Gene ID: (Human) 10894